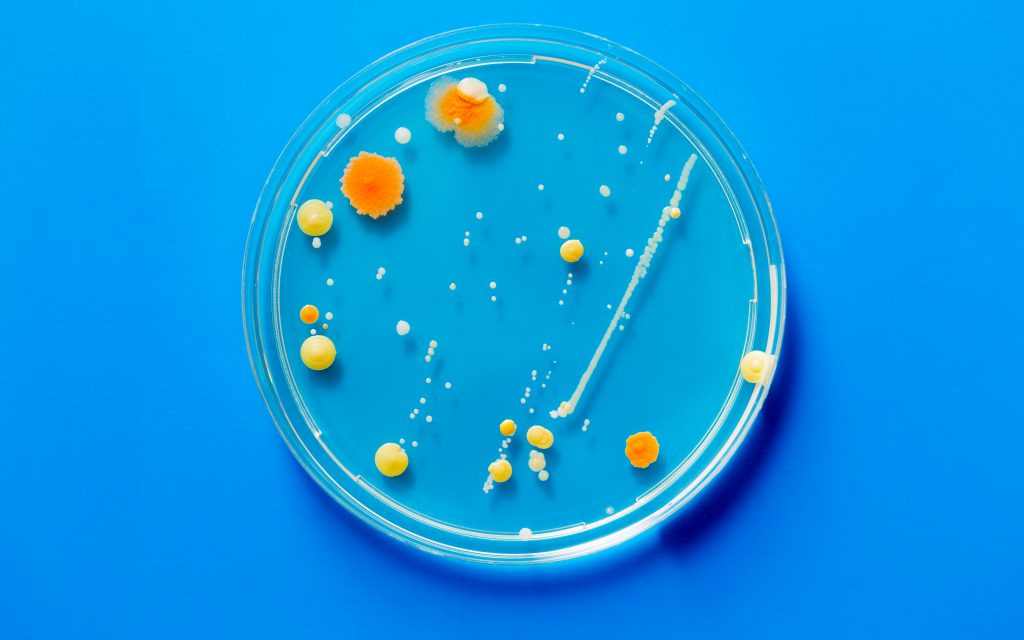

Since the dawn of the industrial age, the world has been powered by a relatively small set of technologies. The 20th century was the age of coal, but this side of 2000, that’s changed.
The need to curb emissions and the rise of renewables, from wind to solar to biomass, has significantly changed how we fuel our power generation.
Today, some of the world’s most interesting and exciting emerging technologies are those designed to generate electricity.
Microbial fuel cells – harnessing the power of bacteria
Bacteria are all around us. Some are harmful, some are beneficial, but all of them ‘breathe’. When they breathe oxidation occurs, which is when something combines with oxygen at a chemical level, and when bacteria do this, electrons are released.
By connecting breathing microbes to a cathode and an anode (the positive and negative rods of a battery), the flow of these released electrons can be harnessed to generate power. This is what’s known as a microbial fuel cell (MFC). MFCs are used largely to generate electricity from waste water, but are expanding into more exotic uses, like powering miniature aquatic robots.
New developments are constantly expanding the power and applications of MFCs. Researchers at Binghamton University, New York found that combining phototropic (light-consuming) and heterotrophic (matter-consuming) bacteria in microbial fuel reactions generates currents 70 times more powerful than in conventional setups.
Solar – a new dawn
Solar power may not be a new technology, but where it’s going is.
One of the most promising developments in the space is solar voltaic glass, which has the properties of a sheet of window glass but can also generate solar power.
Rather than collecting photons like normal solar does (and which transparent materials by definition can’t do) photovoltaic glass uses salts to absorb energy from non-visible wavelengths and deflects these to conventional solar cells embedded at the edge of each panel.
Or there’s solar PV paint, which contains tiny light sensitive particles coated with conductive materials. When layered over electrodes you’ve got a spray-on power generator.
Betavoltaics – nothing wasted from nuclear waste
Nuclear material is constantly decaying and in the process emits radioactive particles. This is why extremely radioactive material is so dangerous and why properly storing nuclear waste is so important and so expensive. But this waste can actually be put to good use. Betavoltaic devices use the waste particles produced by low-level radioactive materials to capture electrons and generate electricity.
The output from these devices can be fairly low and decreases over long periods of time, but because of the consistent output of nuclear decay they can be extremely long-lasting. For example, one betavoltaic battery could provide one watt of power continuously for 30 years.
And while they aren’t currently fit to work on a large scale, their longevity (and very compact size) make them ideal power sources for devices such as sensors installed on equipment that needs to be operational for long periods.

Tidal power – changing tides
A more predictable power source than intermittent renewables like wind and solar, tidal power isn’t new, however its growth and development has typically been restrained by high costs and limited availability. That’s changing. Last year saw the launch of the first of 269 1.5 MW (megawatt) underwater turbines, part of world’s first large scale tidal energy farm in Scotland.
Around the world there are existing tidal power stations – such as the Sihwa Lake Tidal Power Station in South Korea, which has a capacity of 254MW – but the MeyGen array in Scotland will be able to take the potential of the technology further. It’s hoped that when fully operational it will generate 398MW, or enough to power 175,000 homes.
We might not know exactly how the electricity of tomorrow will be generated, but it’s likely some or all of these technologies will play a part. What is clear is that our energy is changing.